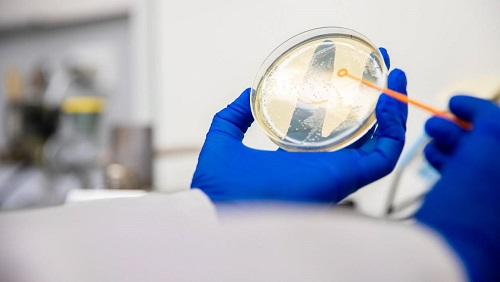
1577739100151 2a

Gonorrhoea is a common sexually transmitted infection (STI) that is becoming increasingly difficult to treat due to rising antibiotic resistance. At the same time, infection rates are increasing in Aotearoa New Zealand and globally. Early diagnosis is critical to limit transmission and reduce unnecessary antibiotic use, but current tests require laboratory processing and results can take several days. This project aims to develop the foundations for a rapid, clinic-based test for gonorrhoea similar to a COVID-19 RAT. We are designing small, highly-specific molecules called nanobodies that bind to conserved surface antigens on Neisseria gonorrhoeae, enabling its detection. We will evaluate their stability and binding performance to identify the best candidates for diagnostic development. The long-term goal is to support faster diagnosis and treatment, reduce the spread of gonorrhoea, and improve sexual health, especially for communities that face barriers to accessing STI testing.

PROJECT DURATION 2025 - 2026